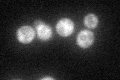
YIL038C
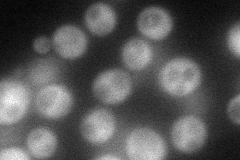
YIL038C
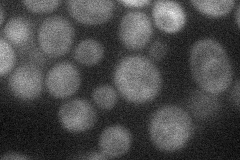
YIL038C
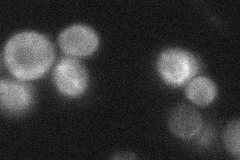
YIL038C
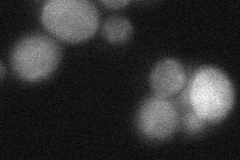
YIL038C
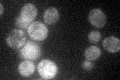
YIL038C

View description
Subunit of the CCR4-NOT complex, which is a global transcriptional regulator with roles in transcription initiation and elongation and in mRNA degradation
Localization:
Intensity:
Fold change:
Significance:
-
C’ GFP library in SD
cytosol48.71 -
N' NOP1pr-GFP in SD
cytosol79.3946 -
N' TEF2pr-mCherry in SD
cytosol23.6416 -
N' NATIVEpr-GFP in SD
cytosol18.7455 -
N' TEF2pr-VC and Cyto-VN in SD
cytosol34.233 -
C’ GFP library in SD+DTT

cytosol44.690.91No -
C’ GFP library in SD+H2O2

cytosol49.511.01No -
C’ GFP library in Starvation Media
cytosol46.170.94No -
C’ GFP library on the background of Pup2-DaMP

N/A -
C’ GFP library on the background of CCT mutant

N/A0N/AYes
